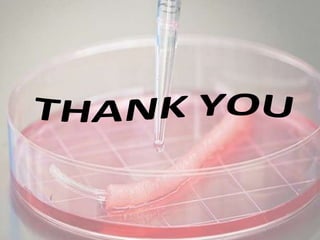
Organ and tissue engineering,examples,

Tissue engineering combines cells, engineering, and materials to improve or replace biological tissues, utilizing scaffolds to support new tissue formation. Applications include artificial organs and repair of damaged tissues, with advantages such as high success rates and reduced dependency on donor organs, although challenges persist including ethical concerns and high costs. Ethical issues surrounding the use of human cells and commercialization risks have emerged, along with innovative artistic projects exploring tissue technologies.